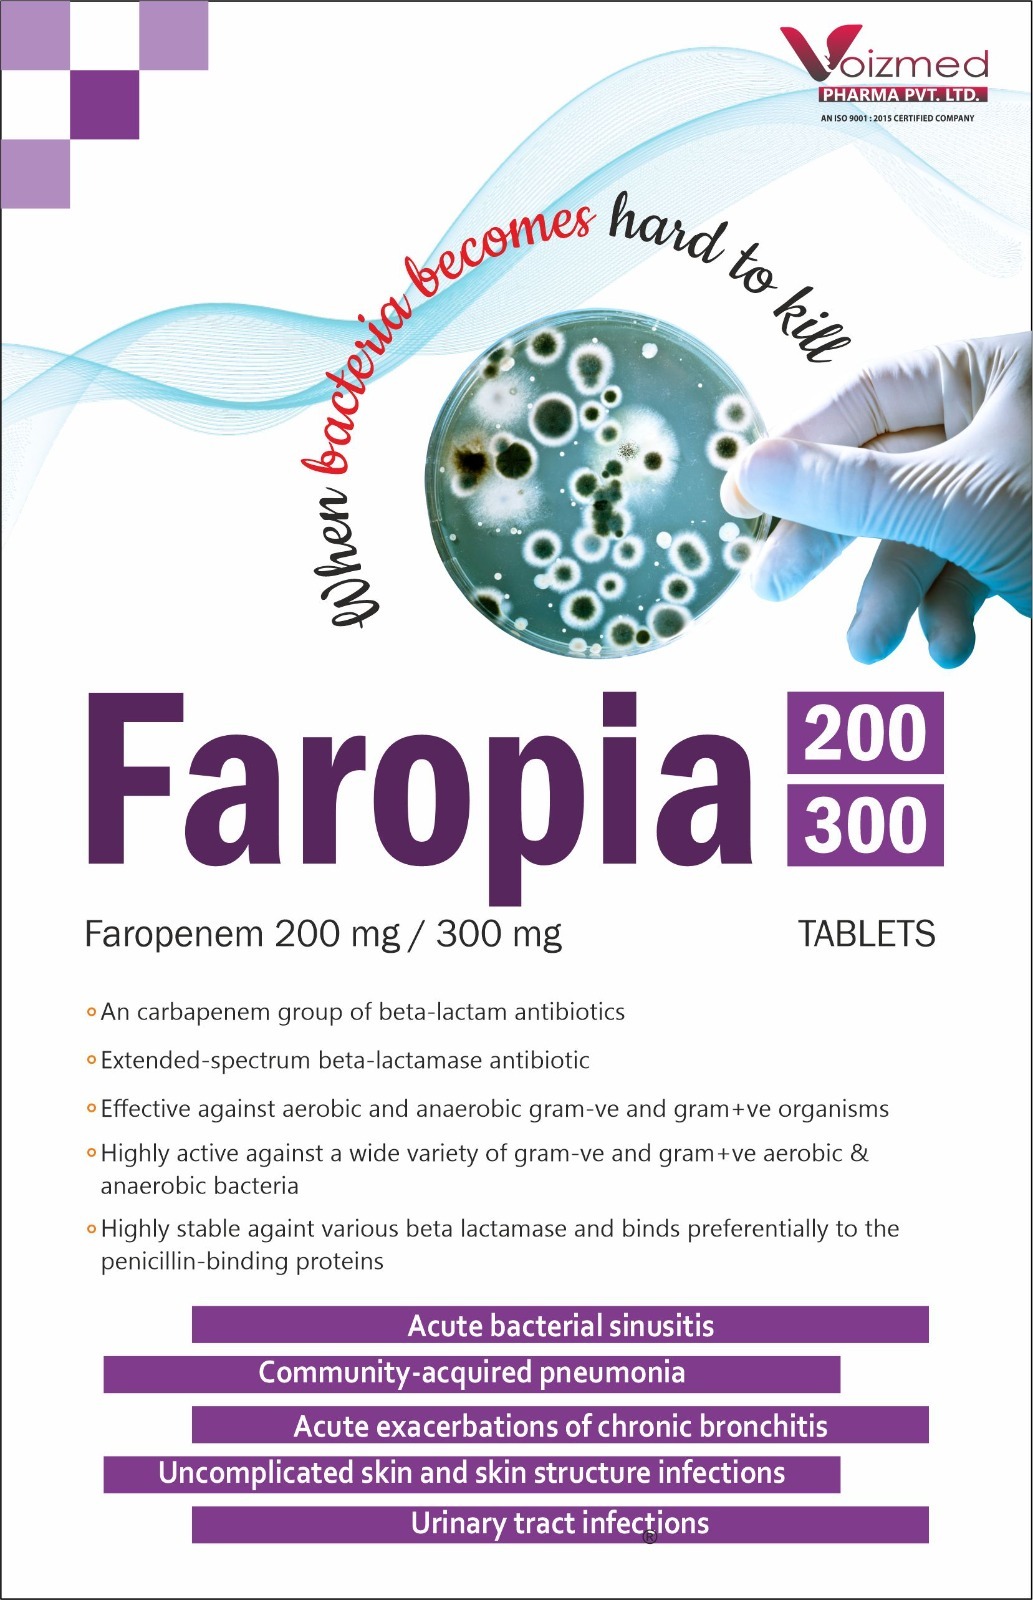
Faropenem 300 mg

Product Details :
|
Brand |
FAROPIA-300 |
|
Composition |
Faropenem 300 mg |
|
Packaging |
6*10 |
|
Form |
TAB
|
|
Packaging type |
BOX
|
|
Function |
ANTIBIOTIC |
|
Application |
Clinic, Hospital |
|
Prescription/Non prescription |
Prescription |
|
Medicine Type |
Allopathic |
|
Manufacturer |
Voizmed Pharma Pvt. Ltd. |
|
Country of Origin |
Made in India |

Price:
Price 1800 INR / Box
Minimum Order Quantity : 1000 Boxes
Physical Form : Tablets
Ingredients : Ferrous Bisglycinate, Zinc Bisglycinate, Folic Acid, Methylcobalamin
Storage Instructions : Store in a cool, dry place, away from direct sunlight
Drug Type : General Medicines
Price 700 INR / Box
Minimum Order Quantity : 200 Boxes
Physical Form : Tablets
Ingredients : Azithoromycin 250mg
Storage Instructions : cool & dry
Drug Type : General Medicines
Price 1100 INR / Unit
Minimum Order Quantity : 1000 Boxes
Physical Form : Tablets
Ingredients : Febuxostat 40 mg
Storage Instructions : Dry Place
Drug Type : General Medicines
Price 900 INR / Box
Minimum Order Quantity : 200 Boxes
Physical Form : Tablets
Ingredients : Diclofenac sodium 50mg+Paracetamol 325mg+Serratiopeptidase 15 Mg(Blister Pack)
Storage Instructions : Keep in a dry & cool place
Drug Type : General Medicines